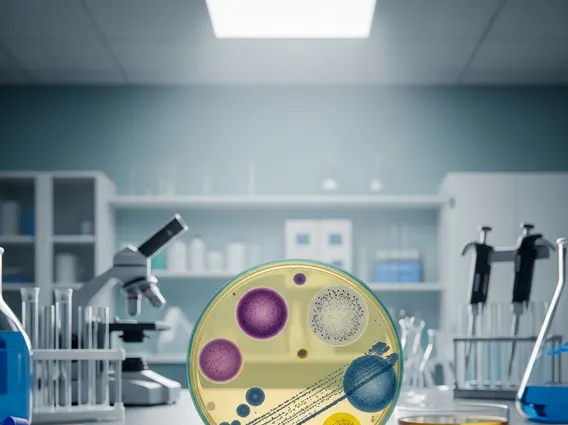

Bacterial Toxin
Bacterial toxins are potent substances produced by bacteria that can cause significant harm to host cells and tissues, playing a crucial role in the development of infectious diseases. Understanding these toxins is vital for diagnosing, treating, and preventing bacterial infections.
Key Takeaways
- Bacterial Toxin refers to poisonous substances produced by bacteria, acting as key virulence factors.
- These toxins exert their effects by damaging host cells, disrupting physiological processes, or overstimulating the immune system.
- They are broadly classified into two main categories: exotoxins (secreted proteins) and endotoxins (components of the bacterial cell wall).
- Mechanisms of action vary widely, including membrane disruption, inhibition of protein synthesis, and modulation of host signaling pathways.
- Knowledge of bacterial toxins is fundamental for developing effective antimicrobial therapies, antitoxins, and vaccines.
What is Bacterial Toxin?
A Bacterial Toxin is a poisonous substance produced by bacteria that contributes to the pathogenicity of an infection by damaging host tissues or interfering with normal cellular functions. These toxins are considered major virulence factors, meaning they are components that enable bacteria to colonize a host, evade immune defenses, and cause disease. The bacterial toxin definition and examples encompass a wide range of molecules, from proteins secreted by living bacteria to structural components released upon bacterial cell lysis.
The production of toxins allows bacteria to establish infections and overcome host defenses. For instance, some toxins facilitate bacterial spread through tissues, while others directly kill host cells or disrupt vital physiological processes. According to the World Health Organization (WHO), bacterial infections, often mediated by toxins, remain a leading cause of morbidity and mortality worldwide, highlighting the significant impact of these bacterial products on global health.
Mechanisms of Bacterial Toxin Action
Bacterial toxins affect the body through diverse and intricate mechanisms, leading to a spectrum of clinical manifestations. These mechanisms often involve specific interactions with host cell components, disrupting normal cellular machinery or triggering harmful immune responses. The precise way a toxin acts determines the specific symptoms and pathology observed in an infected individual.
Common mechanisms by which bacterial toxins exert their effects include:
- Membrane Disruption: Some toxins form pores in host cell membranes, leading to cell lysis and death. Examples include hemolysins, which target red blood cells, and leukocidins, which target white blood cells.
- Enzymatic Activity: Many toxins possess enzymatic activity that modifies host proteins, altering their function. For instance, some toxins are ADP-ribosyltransferases, which inactivate crucial host proteins involved in cell signaling or protein synthesis.
- Signal Transduction Interference: Toxins can manipulate host cell signaling pathways, leading to uncontrolled fluid secretion (as seen with cholera toxin) or paralysis (as seen with botulinum toxin).
- Immune System Modulation: Certain toxins, known as superantigens, can overstimulate the host’s immune system, leading to an excessive inflammatory response that can result in fever, shock, and organ damage.
These varied mechanisms underscore the sophisticated ways bacteria have evolved to exploit host vulnerabilities, making bacterial toxins potent agents of disease.
Classification and Functions of Bacterial Toxins
The types of bacterial toxins and their functions are broadly categorized into two main groups: exotoxins and endotoxins. This classification is based on their chemical nature, origin within the bacterial cell, and mode of release.
Exotoxins
Exotoxins are soluble proteins secreted by living bacteria into their environment. They are highly potent and often have specific targets and mechanisms of action. Exotoxins are typically heat-labile, meaning they can be denatured by heat, and can be neutralized by antitoxins (antibodies). Many vaccines, such as those for diphtheria and tetanus, are based on inactivated exotoxins called toxoids.
Examples of exotoxins and their functions include:
| Toxin Type | Bacterial Source (Example) | Primary Function/Effect |
|---|---|---|
| Neurotoxins | Clostridium botulinum, Clostridium tetani | Interfere with nerve impulse transmission, causing paralysis (flaccid or spastic). |
| Enterotoxins | Vibrio cholerae, enterotoxigenic E. coli | Act on the gastrointestinal tract, causing fluid secretion and diarrhea. |
| Cytotoxins | Corynebacterium diphtheriae, Staphylococcus aureus | Directly kill host cells or inhibit their protein synthesis, leading to tissue damage. |
| Superantigens | Staphylococcus aureus, Streptococcus pyogenes | Overstimulate the immune system, leading to excessive inflammation and toxic shock. |
Endotoxins
Endotoxins are structural components of the outer membrane of Gram-negative bacteria, specifically the lipid A component of lipopolysaccharide (LPS). Unlike exotoxins, endotoxins are not actively secreted but are released primarily when bacterial cells lyse, such as during antibiotic treatment or immune clearance. They are heat-stable and generally less potent than exotoxins, but can trigger a strong, non-specific inflammatory response.
When released into the bloodstream, endotoxins can activate immune cells, leading to the release of inflammatory mediators. This can result in systemic effects such as fever, hypotension, disseminated intravascular coagulation (DIC), and potentially septic shock, a life-threatening condition. The widespread impact of endotoxins on the body makes them a significant concern in Gram-negative bacterial infections.



















